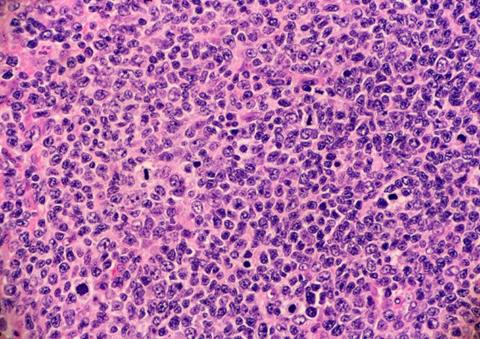
Image

Following the CHMP’s recommendation of a follicular lymphoma combination treatment, if approved, BRUKINSA will be the first BTK inhibitor to be authorised for follicular lymphoma.
The Committee for Medicinal Products for Human Use (CHMP) has recommended approval of BRUKINSA® (zanubrutinib), a Bruton’s tyrosine kinase inhibitor (BTKi), in combination with obinutuzumab. BeiGene’s anti-cancer treatment is indicated for adults with relapsed or refractory (R/R) follicular lymphoma (FL) who have received at least two prior lines of systemic therapy.
In January this year, BRUKINSA was authorised by the Medicines and Healthcare products Regulatory Agency (MHRA) for chronic lymphocytic leukaemia (CLL) and marginal zone lymphoma (MZL).
BRUKINSA is currently approved in the EU for the treatment of adults with another blood cancer, Waldenström’s macroglobulinemia, who have received at least one prior therapy or as first-line treatment for patients who are unsuitable for chemo-immunotherapy.
Advancing treatments for follicular lymphoma
Despite advances in the treatment landscape, follicular lymphoma patients “often relapse and experience shorter response times to subsequent treatments,” according to Dr Mehrdad Mobasher, Chief Medical Officer of Hematology at BeiGene.
Therefore, the CHMP’s positive opinion means there is potential for another option to become available in the oncology treatment landscape. “if approved in follicular lymphoma – [BRUKINSA] will become the BTK inhibitor with the broadest label in the EU,” stated Dr Mobasher. Specifically, it would be the first medicine of this type to be authorised for four indications.
Clinical data on which the CHMP’s opinion of BRUKINSA is based
Recommendation of BRUKINSA plus obinutuzumab is based on positive results from the ongoing ROSEWOOD Phase II study and supported by the Phase Ib BGB-3111-GA101-001 study which compared the combination treatment to obinutuzumab monotherapy in 217 patients.
The overall response rate (ORR) in the study was found to be 69.0 percent in the BRUKINSA plus obinutuzumab arm. For patients only treated with obinutuzumab, the ORR was 45.8 percent. The median follow-up was approximately 20 months.
BRUKINSA plus obinutuzumab was generally well-tolerated, with safety results consistent with previous studies of both medicines, the results showed.
According to BeiGene, the European Commission will now consider its Marketing Application. A final decision, expected within 67 days, will be applicable to all 27 member states of the EU, plus Iceland and Norway.
Topics
- Anti-Cancer Therapeutics
- BeiGene
- Bioprocessing and biomanufacturing
- Blood cancer
- BRUKINSA® (zanubrutinib)
- Cancer
- Clinical Development
- Clinical Trials
- Committee for Medicinal Products for Human Use (CHMP)
- Data Analysis
- Dr Mehrdad Mobasher
- Drug Development
- Drug Markets
- European Commission (EC)
- Follicular Lymphoma
- Formulation and drug delivery
- obinutuzumab
- Pharmacovigilance and safety oversight
- Regulation and compliance
- Therapeutics















